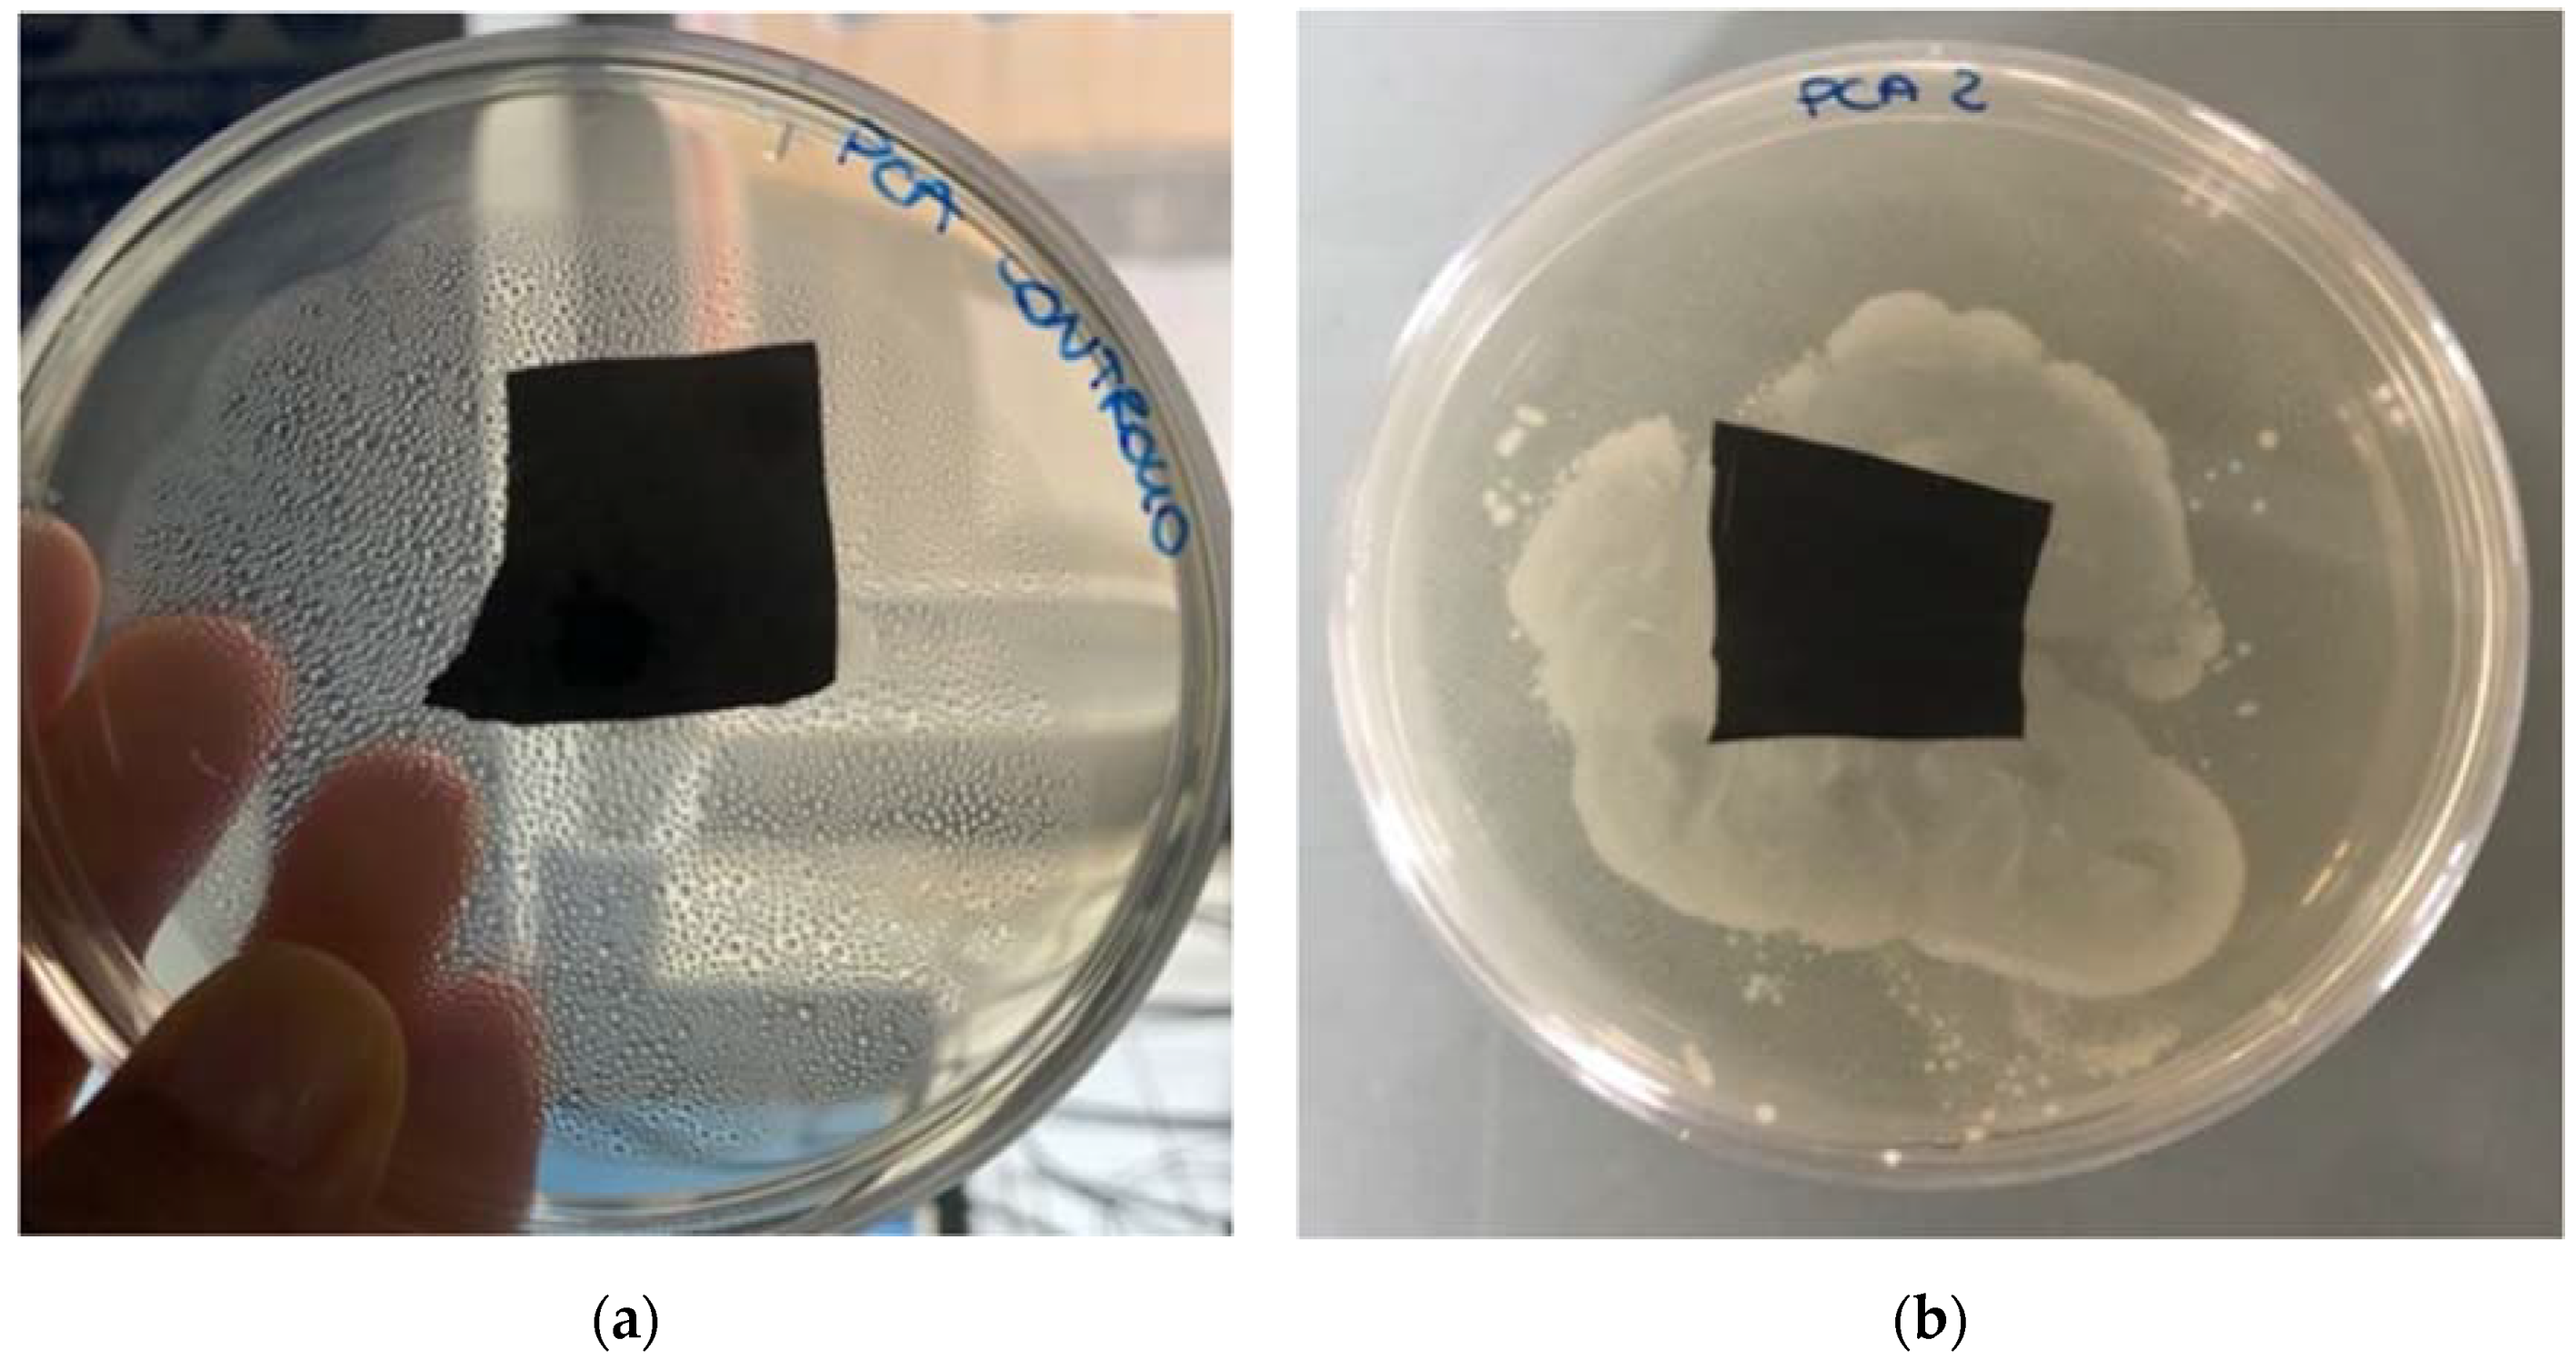
Agriculture 11 00782 g003 550

1. Introduction
Agricultural plastic mulch films are commonly used for covering cultivated fields to reduce weed pressure, preserve soil structure, maintain soil temperature, improve moisture conservation and increase crop yields [
1,
2]. Most mulch films are synthetic polymers produced from petroleum-based plastics, such as polyethylene (PE), polypropylene (PP), polyvinyl chloride, polyethylene terephthalate (PET), etc., which are characterized by low costs, ease of manufacture and good versatility [
3]. Given the high number of benefits, in the last twenty years, the use of plastic mulches derived from man-made long-chain polymeric molecules has increased dramatically, mainly in the USA and Western Europe. Furthermore, the production of plastic mulches is expected to triple by 2050, thus needing the 20% of the annual global oil consumption for their synthesis [
4]. The widespread use of plasticulture in agriculture caused many environmental problems, not only for the high greenhouse gas (GHG) emissions, but also for the depletion of fossil resources, as well as for the removal and disposal of plastic films after use [
5].
To address the agricultural plastic waste problem, several environmentally degradable polymeric materials and plastics have been developed since the 1980s and have gained in popularity. Biodegradable plastics (BPs), i.e., biopolymers synthetized by renewable biomass or mimicking microorganisms, exhibit a significant degradation rate, so that, at the end of their life, they can be directly integrated into the soil, thus representing a sustainable alternative to petroleum-based plastics [
6]. BPs, in fact, can be degraded by extracellular depolymerases secreted by microbes (bacteria, fungi or algae) into oligomeric or monomeric units [
7]. Nowadays, BPs account for about 0.5% of the total annual plastic production, but the European Bioplastics [
8] (2019) esteemed that BP production will increase to about 2.43 million tons in 2024.
The most prominent role in BPs production is played by aliphatic and aromatic polyesters: polyhydroxyalkanoate (PHA), polylactic acid (PLA), polybutylene succinate (PBS), polyhydroxybutyrate (PHB), etc. Commercially available BPs are often blended with starch, natural fibers or other polymers (e.g., fillers, plasticizers and dyes) to control and increase their degradable rate after use [
9]. BPs can be grouped into microbial synthetic plastics, natural polymer plastics and synthetic biodegradable plastics [
10]. The first two typologies of BPs are completely biodegradable, while the latter are destructive biodegradable plastics. Ideally, a PB should have excellent physicochemical and mechanical properties, a programmed degradability and a 100% post-use biodegradability. However, biodegradation, defined as the conversion of plastic monomers or polymers into biomass, CH
4, CO
2 and H
2O through biological processes, cannot be controlled in natural environments [
11]. Indeed, biodegradation occurs via various mechanisms, from abiotic processes (photolytic, thermal, mechanical and hydrolytic) to biological degradation (mineralization) and it is governed by different factors, including polymer characteristics (mobility, tacticity, crystallinity, molecular weight and type of functional groups), nature of pre-treatment, type of organism and environmental conditions [
10,
11]. Generally, biodegradation involves three stages [
12]: (i) biodeterioration (aggregation of microorganisms on the surface of BPs and abiotic degradation of mechanical properties), (ii) biofragmentation (fragmentation of polymers into oligomers by depolymerases) and (iii) bioassimilation (break down of oligomers into monomers, biomass, CO
2 and H
2O).
Unfortunately, only few studies have been published on microbial biodegradation of BPs in soil environments and under soil crop conditions [
2,
9,
13]. Among these few studies, none identified and isolated the microbial communities directly associated with BPs. On the contrary, most studies characterized the microorganisms near BPs [
14] and were focused only on fungi [
2,
13,
15]. Therefore, a significant knowledge gap exists in the identification of the specific microbial taxa involved in biodegradation, especially regarding bacteria, as well as in the microorganisms directly colonizing BPs. Given these considerations, the present research aims at (1) evaluating the effect of biodegradable mulching on soil microorganisms and (2) isolating and identifying the microorganisms potentially responsible of degradation under field conditions. We tested the hypothesis that soil microorganisms would degrade BPs and, therefore, our goal was to isolate the microorganisms showing degradative abilities and to quantify them in the soil.
2. Materials and Methods
2.1. Site, Soil, Climate and Soil Temperature
The field trial occurred in central Sicily (37°13′ N, 14°05′ E, 290 m a.s.l., southern Italy) within an apricot (
Prunus armeniaca L.) field located in an area devoted to typical Mediterranean crops. The soil at the site was a clayed textured Regosoil [
16] with 18.3% sand, 24.3% silt and 57.4% clay, 1.7% organic matter, 9.5% active limestone, an average pH of 8.0 and 1.3‰ total N, 23 mg
−1 kg
−1 assimilable P
2O
5 and 622 mg
−1 kg
−1 exchangeable K
2O. The climate was semiarid Mediterranean. Daily rainfall, maximum, average and minimum air temperatures from October 2019 to February 2021, were measured with a meteorological station (Mod. Multirecorder 2.40; ETG, Firenze, Italy) sited at ~15 m from the experimental site. In the same period, the soil temperature was also measured on 7-day intervals at two depths (−10 cm and −20 cm) using a FieldScout EC 450 Meter (Spectrum Technologies, Inc., Aurora, Illinois, U.S.A.; accuracy: ±1%). At −10 cm, compared to the conventional management (CM, 23.6 °C), it was found that the average soil temperature was −2.1 °C in TCC-S, −1.9 °C in TCC-B, +5.9 °C in nBP and +4.1 °C in BP. At −20 cm, compared to CM (22.0 °C), soil temperature was −2.3 °C in TCC-S, −2.0 °C in TCC-B, +4.5 °C in nBP and +3.2 °C in BP.
2.2. Experimental Design and Agronomic Management
The experiment was a randomized complete block design with three replications of five main plots treatments (20 × 10.8 m for each plot) totaling to 15 plots, 216 m
2 per treatment and 3240 m
2 in total. Treatments included (1) a BP and (2) a no-BP (nBP), (3) a subterranean clover (
Trifolium subterraneum L.) cover cropping with soil-surface application of dead mulches (TCC-S) (4) and a subterranean clover cover cropping with soil-incorporation of dead mulches (TCC-B). TCC-S and TCC-B were chosen as they represent a valid agronomic tool in
P. armeniaca orchards to improve weed control [
17], soil mineral nitrogen [
18] and the nutritional status of the trees [
19]. These treatments were compared to (5) a conventional management (CM) following the typical agronomic practices for the zone: a winter shallow hoeing at 0.10 m in September, followed by two tine harrowing in February and May to control weeds.
Placement of BP and nBP films occurred in May 2020. BP film was a commercial biodegradable plastic mulch, Agribio® (Agriplast, Vittoria, Italy), according to the normative reference EN 17033, with a thickness of 15 µm and a total visible light emission ≤3%. A no-biodegradable commercial film (nBP) was placed as control, Black 35® (Agriplast, Vittoria, Italy), which was a conventional low-density PE mulch film with a thickness of 35 µm. Apricot cv. Kioto® was planted on January 2018 with a 4.5 × 4.0 m layout, while subterranean clover cv. Mintaro was seeded in October 2019 by adopting a seeding rate of 22.2 kg ha−1. In TCC-S and TCC-B, Rhizobium inoculation was not applied due to previous cultivations of Trifolium spp. These plots received an irrigation up to the field capacity to promote T. subterraneum germination. “Mintaro” is a mid-season Australian cultivar of T. subterraneum var. brachycalycinum with high adaptability in Mediterranean environments, clay and neutral to alkaline soils, good N-fixation and self-reseeding capacity. The total length of the subterranean clover biological cycle was ~210 days, with the emergence occurring in December 2019, the highest vegetative development (~30 cm in height) in March 2020, flowering in April 2020 and total drying of the plants in the first decade of July 2020.
No post-emergence soil tillage was carried out in BP, nBP, TCC-SB and TCC-GM. In all the plots, a self-compensating drip irrigation was used, replacing 100% of the maximum evapotranspiration. About fertilization, N and P2O5 were soil-applied through 50 kg ha−1 Hergoton Plus® (8% total organic N, 26% biologic C and 44.45% total organic matter) and 50 kg ha−1 simple perphosphate, respectively, while Ca was foliar-applied with 150 g hL−1 Biocal® (12% CaO, two times, in April and May 2021). Fungi and insects were controlled with the following commercial organic products, applied as foliar sprays: Cupravit 35 WG® (copper oxychloride 35%, twice in winter at 15 days interval), Thiovit® Jet (80% sulphur, four times at 3 kg ha−1) and LaserTM 240 SC (240 g L−1 spinosad).
2.3. Biodegradation in Plate Assay
In order to identify the soil microbial communities directly associated with biodegradable mulching, several tests were carried out with the aim of isolating and identifying the microorganisms potentially responsible of the degradation process.
Figure 1 shows the general experimental sequence of the activities of our study.
BP samples, which, in the field, appeared partially degraded, were taken from the soil and washed with M9 medium [
20] to recover the microorganisms adhering to the surface and potentially responsible for degradation. An aliquot of the M9 culture broth was used to inoculate NB (Nutrient Broth; Oxoid, Milan, Italy) and YPD (Yeast Extract-Peptone-Dextrose; Oxoid, Milan, Italy), respectively, to allow bacterial and fungal growth. In NB, cycloheximide was added to inhibit fungal growth (100 μg L
−1 added after sterilization); in YPD, chloramphenicol was added to inhibit bacterial growth (100 μg L
−1). Bacterial and fungal broths were incubated at 32 °C for 24 h and 25 °C for 48 h, respectively.
Serial dilutions were made with sterile solution and aliquots of all samples were plated for microbial growth using the spread plate method and distributing 0.1 mL dilutions directly over the surface of the plates. PCA (Plate Count Agar; Oxoid, Milan, Italy) and SDA (Sabouraud Dextrose Agar; Oxoid, Milan, Italy) were respectively used as media for growth of aerobic mesophilic bacteria and fungi. The plates were incubated at the optimum growth temperature for 24 and 48 h, respectively. When microorganism growth was visible on the plates, the streak plate method was used in order to isolate different colony types from the mixed culture and, then, the pure cultures were stored at −80 °C with the addition of 20% sterile glycerol.
Based on the different colony morphology, 6 of the isolated colonies (4 bacteria and 2 fungi) were tested individually on BP samples to understand if they were responsible for degradation. For this purpose, 1.8 × 1.8 cm biodegradable plastic samples were sterilized under UV light, put in the middle of Petri dishes and contaminated with the pure cultures. For the contamination, each pure culture was previously grown in 10 mL of liquid medium (NB for bacteria; YPD for fungi); then, 20 mL of the same medium, with an agar concentration of 30 g L−1, was added to obtain a final agar concentration of 20 g L−1 and, finally, poured into Petri dishes. Samples were placed in a thermostat at 25 °C for fungi and 32 °C for bacteria to favor the growth of microorganisms and verify whether polymer biodegradation occurred. A sterile control was performed to verify if the degradation was only due to microorganism activity. The polymer samples were sterilized under UV light, put in the middle of Petri dishes without any inoculum and incubated in the same conditions as above.
2.4. Biodegradation in Liquid Assay
In order to verify if the 4 bacteria and 2 fungi, isolated as mentioned above, were able to grow using the polymer as sole carbon source, biodegradation tests were performed in M9 and YNB (Yeast Nitrogen Based; Oxoid, Italy) liquid media, where the only carbon source was represented by the presence of polymer samples.
A volume of 50 mL of sterile M9 and YNB media for the bacterial and fungal growth, respectively, was poured in Erlenmeyer flasks and inoculated with the pure culture of the microorganism previously isolated, ranging from 5.1 to 5.4 log CFU mL−1, in presence of plastic film 1.8 × 1.8 cm, previously sterilized under UV light. The samples were incubated aerobically at 32 °C and 25 °C, for bacterial and fungal growth, respectively, in the dark, on a rotary oscillator at 120 rpm. Tests were carried out for 4 weeks. At the end of every week, colony counts were made to verify the microbial growth. Four sampling were totally made, one for each week. Analyses were carried out in triplicate for each material. Population densities were expressed as log10 CFU mL−1 of culture broth.
2.5. Real-Time Quantitative PCR Assay of Pseudomonas putida in Soil
In relation to the obtained results regarding the identification of the “bacterium 4” as
Pseudomonas putida, which was able to degrade BP films, we decided to quantify, by RT-PCR, the above-mentioned bacterium in soil samples in order to monitor its presence over time among the treatments. Prior to RT-PCR, the soil DNA was extracted following Scavo et al. [
21]. The obtained pure DNA was stored at −20 °C until RT-PCR amplification, then it was spectrophotometrically quantified (all with 260:280 ratios above 1.7).
The qRT-PCR is widely used to quantify the PCR product. Data from RT-quantitative PCR experiments were analyzed with the absolute quantification method, which determines the input copy number of the gene of interest by relating the PCR signal to a standard curve [
22]. The qRT-PCR was carried out in accordance with Scavo et al. [
18]. The obtained cycle threshold (Ct) is the number of cycles required for the fluorescent signal to cross the threshold (i.e., to exceed background level). Ct levels are inversely proportional to the amount of target nucleic acid in the sample.
Real-time PCR of P. putida was performed on soil DNA extracts for each treatment at different sampling times (May 2020, October 2020, December 2020 and February 2021) to monitor its abundance. PCR amplification conditions, using SYBR GREEN technology, were 94 °C for 2 min, 40 cycles of 94 °C for 15 s, 55 °C for 40 s, 72 °C for 40 s. Reactions were 25 µL volumes using Platinum Quantitative PCR Supermix-UDG (Invitrogen). For testing the primers, designed as described below, P. putida DNA (DSM 291) was directly used as a source of DNA template in a 25 µL reaction.
The same strain was used as standard for the calibration curve and subsequent calculation of its amount. Standard curves were derived using known amounts of DNA corresponding to 0.001–100 ng of genomic DNA. Threshold cycle (Ct) values were determined, in triplicate, using 2 µL samples of each soil DNA extract per PCR reaction. Ct values were converted to ng of DNA using the equation derived from the standard curve.
Design of Pseudomonas putida-Specific Amplicon
An alignment of the P. putida 16S rRNA gene was analyzed to identify conserved regions suitable for developing an RT-PCR assay for detection of gene sequences specific to this bacterium. Specific forward Pptf (20-mer (5′-AAGCTAGAGTACGGTAGAGG-3′)) and reverse Pptr (20-mer (5′-ACCAGGGTATCTAATCCTGT-3′)) primers were designed to amplify a 154-bp amplicon from the P. putida 16S rRNA gene to allow its quantification.
2.6. Statistical Analysis
An analysis of variance (ANOVA) was conducted using the CoStat
® computer package version 6.003 (CoHort Software, Monterey, CA, USA) to statistically analyze qRT-PCR data. The Bartlett’s and Shapiro–Wilk tests were performed to verify the ANOVA basic assumptions of homoscedasticity and normality, respectively. Prior to ANOVA, qRT-PCR data and populations densities needed a log
10(x + 1)-transformation (untransformed data are reported and discussed), in accordance with Lombardo et al. [
23]. A generalized linear model (GLM) was performed considering the ‘field treatment’ and ‘soil sampling time’ as fixed factors. Means were separated through the Fisher’s protected Least Significant Difference (LSD) test with α = 0.05.
4. Discussion
To evaluate the effect of biodegradable mulching on soil microflora and with the aim of isolating and identifying the microorganisms responsible for degradation, a combined approach, based on biodegradation and molecular tests, was herein described to obtain an overview.
Placement of BP and nBP films in the experimental field occurred in May 2020. The plastic materials were monitored over time. In September 2020, they appeared visibly degraded, with strong evidence of cracks and thinning. It was therefore decided to collect samples from plastics to isolate the microorganisms attached to the surface of the materials. The adopted procedure represents a first-pass technique for isolating potential BP degraders from soil and was successfully used to isolate, from BP, a mesophilic bacterium able to grow using the polymer as the sole carbon source. This microorganism was identified, by sequencing, as
P. putida.
Pseudomonas putida are ubiquitous bacteria frequently present in water, in soils and, especially, in the plant rhizosphere [
24,
25]. These aerobic, Gram-negative
Pseudomonas show diverse spectra of metabolic versatility and niche-specific adaptations [
26,
27]. Some of them may also be involved in the biodegradation of natural or man-made toxic chemical compounds [
28,
29].
Kasirajan and Ngouajio et al. [
1] reviewed a list of BP-degrading microorganisms. However, only few studies report so far the use of microorganisms, in particular fungal strains belonging to
Aspergillus and
Penicillium genera and spore forming bacteria belonging to
Bacillus and
Clostridium genera, to enhance the degradation of used BP mulch films in soil environment [
30]. Indeed, Koitabashi and coauthors [
2] reported a study about the potential of using BP-degrading microorganisms, such as phylloplane fungi isolated from Poaceae members, for accelerating the degradation of used BP mulch films in agricultural fields. The authors isolated the strain B47-9 from healthy leaves of barley, that could be safely utilized for acceleration of degradation of BP mulch film after use. Furthermore, Fukushima et al. [
31,
32] found that the bacterium
B. licheniformis was among those responsible for the biodegradation of poly(lactic acid) and poly(ε-caprolactone) and their nanocomposites in a mature compost. Recently, Bandopadhyay et al. [
9] combined the amplicon sequencing and the qPCR to study the soil microbial communities associated with BPs and nBPs in two locations. They found a higher presence of
Methylobacterium,
Arthrobacter and
Sphingomonas in BP soils than nBP ones, also reporting these microbial consortia were able to degrade the plastics.
In our research, we found that the isolate
P. putida showed a high ability to use BP film both in plate and liquid assays. In the plate assay, the isolated bacterium colonized BP sample with a strong evidence of a growth halo surrounding the polymer. In the liquid assay, its ability to use BP as carbon and energy sources was confirmed with an increase in the population density from the initial contamination of 5.1 to 7.9 log CFU mL
−1 after 4 weeks. In order to understand if the in vitro obtained results reflected the behavior of
P. putida in the experimental field and to assess the effect of biodegradable mulching on this microorganism, its quantification by RT-PCR was performed in soil samples over the time periods in between treatments. The qRT-PCR technology has been recently used to rapidly quantify microorganisms associated with biodegradable plastic mulch films in soil [
9]. In our work, a higher amount of
P. putida in BP plots was detected, compared to the other treatments. This was probably due to carbon availability, on one hand, and to the increase of soil temperature, on the other. Indeed, it is well-known that soil temperature is one of the most important factors affecting microorganism growth. Here, BP caused a +4.1 °C in the 0–10 cm soil depth and a +3.2 °C in the 0–20 cm layer, in respect to CM. Brodhagen and coauthors [
7] have fully reported that temperature is one of the factors driving microbial metabolism and affecting the biodegradation rate. Biologically, the enhancement of enzymatically catalyzed reactions by warmer temperatures results in an increase in the overall metabolic rate of microbial communities, which implies increased production of cells and enzymes. Overall, our results indicate the ability of the mesophilic
P. putida to proliferate and actively degrade the commercial BP film in agricultural soils.